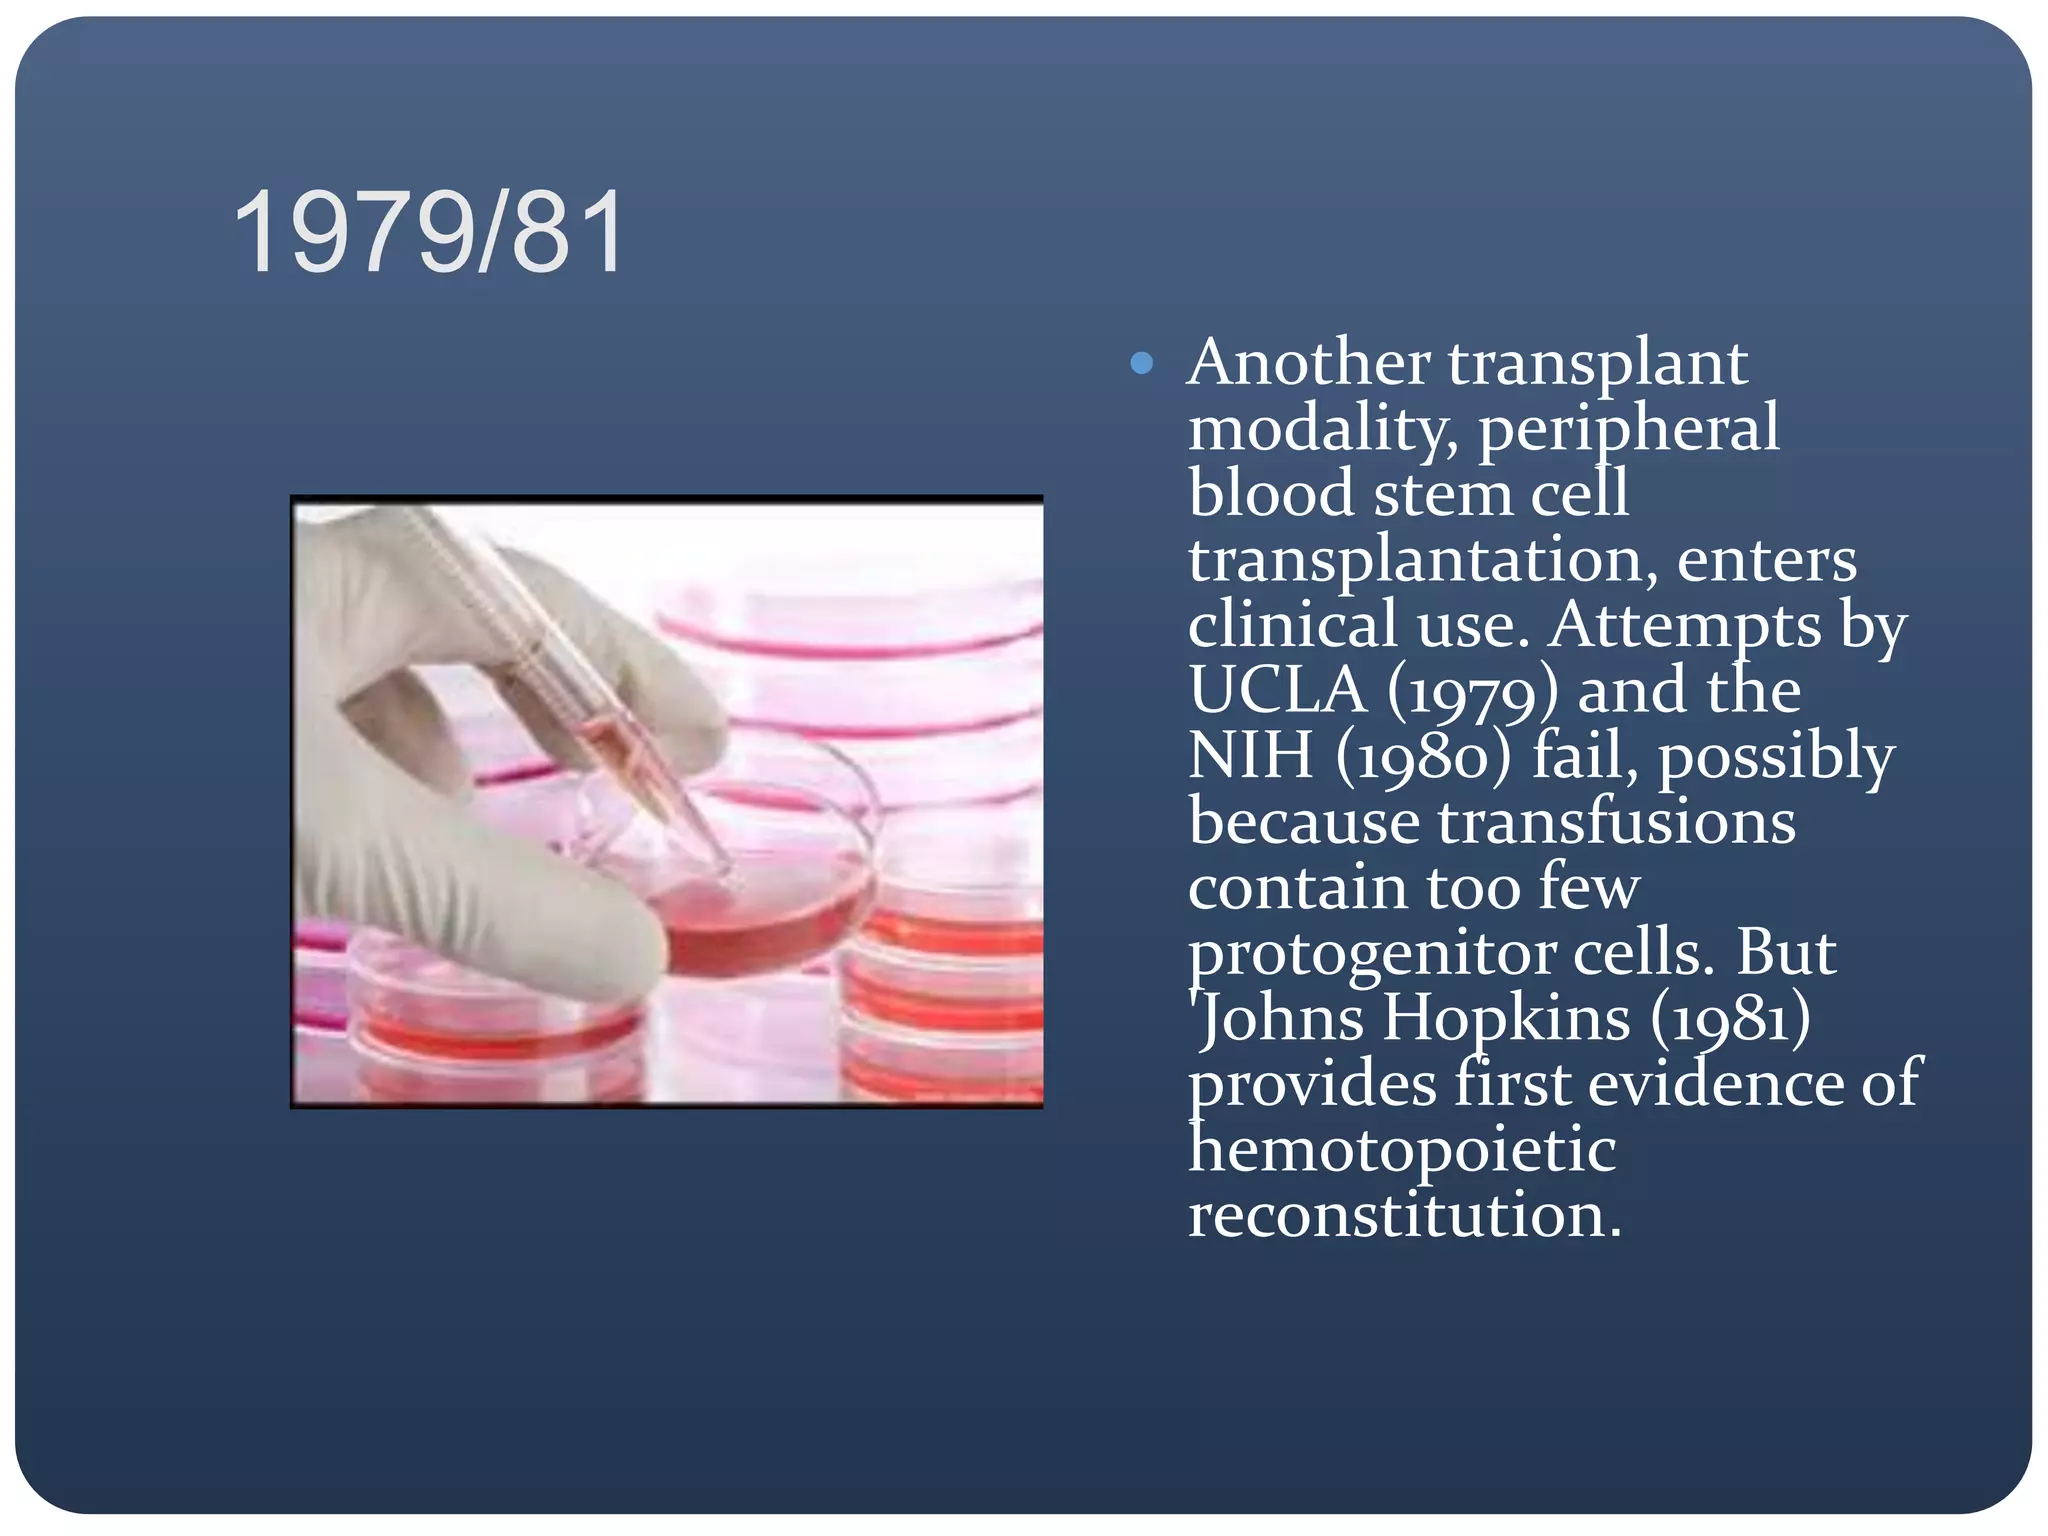
1979/81
 Another transplant
modality, peripheral
blood stem cell
transplantation, enters
clinical use. Attempts by
UCLA (1979) and the
NIH (1980) fail, possibly
because transfusions
contain too few
protogenitor cells. But
'Johns Hopkins (1981)
provides first evidence of
hemotopoietic
reconstitution.

This document provides a timeline of major developments in stem cell research from 1950 to 2013. Some key events include:
- In the 1950s, the first bone marrow transplants were performed in humans and between identical twins, demonstrating that bone marrow could reconstitute the hematopoietic system.
- In the 1960s, scientists showed that stem cells can self-renew and differentiate, and developed assays to study hematopoietic stem cells.
- In the 1970s-1980s, techniques were developed to isolate and culture hematopoietic stem cells from mice and study hematopoiesis in vitro.
- In the 1990s-2000s, embryonic stem cells were derived from non-human